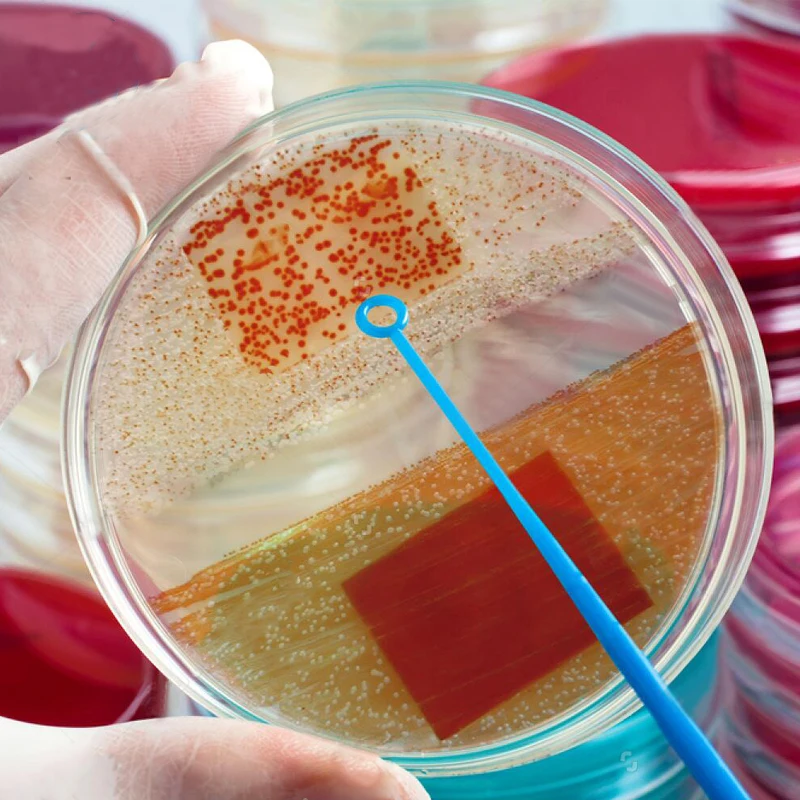

Одноразовая пластиковая чаша Петри 20 шт./упак. 60 мм лабораторное оборудование
Сохраните в закладки:



История цены
*История изменения цены! Указанная стоимость возможно, уже изменилось. Проверить текущую цену - >
| Месяц | Минимальная цена | Макс. стоимость | Цена |
|---|---|---|---|
| Aug-15-2025 | 791.87 руб. | 807.64 руб. | 799 руб. |
| Jul-15-2025 | 642.79 руб. | 655.9 руб. | 648.5 руб. |
| Jun-15-2025 | 779.11 руб. | 795.46 руб. | 787 руб. |
| May-15-2025 | 773.4 руб. | 788.93 руб. | 780.5 руб. |
| Apr-15-2025 | 617.76 руб. | 629.78 руб. | 623 руб. |
| Mar-15-2025 | 760.74 руб. | 775.91 руб. | 767.5 руб. |
| Feb-15-2025 | 754.95 руб. | 769.97 руб. | 761.5 руб. |
| Jan-15-2025 | 748.85 руб. | 763.88 руб. | 755.5 руб. |
Новые товары
Ячейка JGS1 кварцевая кювета с пробкой внутренняя ширина 3 мм 1050ul - купить по
Стеклянная многоразовая тарелка Петри для культуры миска с крышкой химической
5 шт. прозрачная стеклянная посуда для лабораторных часов крышка стакана
250 мл фарфоровое Испаряющее блюдо круглое дно химическое покрытие диаметр 111 мм -
SOSW-10 шт 60 мм x 15 полистирол стерилизованные чашки Петри с крышками - купить по
5 шт. стеклянные чаши Петри из боросиликата для выращивания клеток школы - купить
Контактная Пластина Rodac 1000 шт./лот 55 мм для поверхностного микробного отбора проб
FTO покрытое проводящее стекло 50*50*2 2 мм 7-10 Ом/кв 10 шт. лабораторное прозрачное
Характеристики
Одноразовая пластиковая чаша Петри 20 шт./упак. 60 мм лабораторное оборудование
Описание товара
20 шт./упак. 60 мм Одноразовые Пластик чашка Петри лабораторное оборудование чашка для культивирования
10 шт./упак. 2 пакета/упаковка



Трекер стоимости
Отзывы покупателей
Новые отзывы о товарах
Для моего ультрабука Hp Pavilion 15.6 дюймового эта сумка хорошо подошла. Мне понравилось качество сумки, можно туда же положить зарядку... Читать отзыв полностью...
Платье заказывала для себя в двух экземплярах-сирене вое и желтое. Доставили оперативно. Подошло идеально, размер соответствует. Материал очень приятный на... Читать отзыв полностью...
Очень долго искала такое платье, хотелось что-то простое но интересное, и вот наткнулась на него, заказала, спасибо за быструю доставку.... Читать отзыв полностью...
Платье очень деликатное и умело подчеркивает все достоинства фигуры, особенно талию. Отлично подойдет как в офис, так и на прогулку... Читать отзыв полностью...
Наконец то я приобрела очки, о которых давно мечтала. Спасибо продавцу. Цена радует меня. Качество очень хорошее. На лето... Читать отзыв полностью...
Я занимаюсь ремонтом ноутбуков. Мне нужно было заменить клавиатуру на ноутбуке ASUS F80. Нашел подходящую клаву черной версии, как и... Читать отзыв полностью...

Здравствуйте! хочу оставить отзыв, очень тёплая жилетка, что мне нравится так это то что длина жилета до колен. Очень удобно... Читать отзыв полностью...